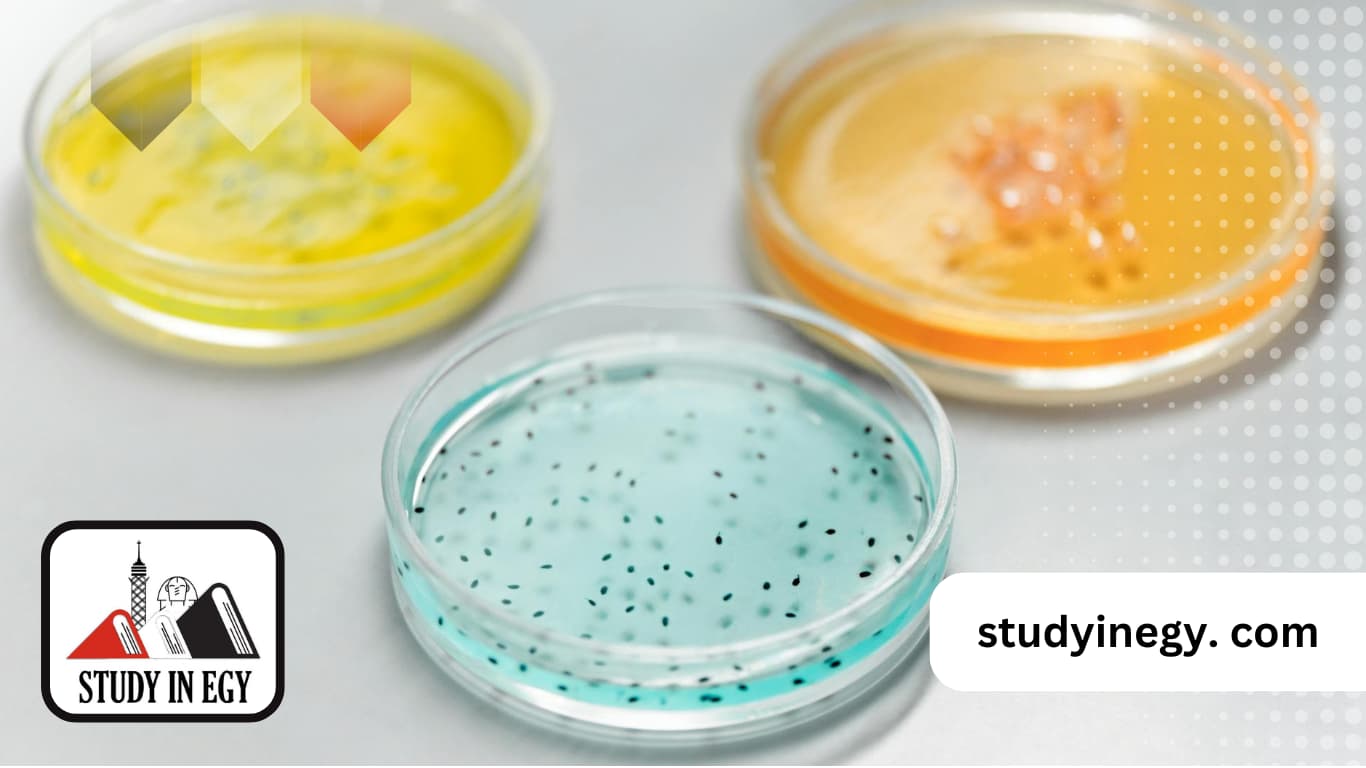
دكتوراه مختبرات طبية في مصر

يتساءل العديد من الطلاب العرب والباحثين عن برنامج “دكتوراه مختبرات طبية” بكثرة، رغبة منهم في الالتحاق ببرنامج أكاديمي يضمن لهم تحقيق الموازنة بين (الاعتراف الرسمي – الجودة العلمية – التطبيق العملي المقدمة – التكلفة الاقتصادية)، والجامعات المصرية من أبرز الوجهات الأكاديمية لتقديم هذا التخصص في جامعاتها الحكومية والخاصة بفرص بحثية مميزة وشروط مرنة للوافدين.
وللإجابة عن كافة التساؤلات التي قد تخطر بالبال، يستعرض هذا المقال تفاصيل شاملة حول نواياهم البحثية: الاعتراف، شروط القبول، تكلفة الدراسة، ومدتها، وأفضل الجامعات، و التخصصات المتاحة بها، وفرص العمل أيضا.
الاعتراف بشهادة دكتوراه مختبرات طبية في مصر محليًا ودوليًا
أول ما يرغب في معرفة الطالب الوافد لدراسة برنامج الدكتوراه في مصر هو معادلة الشهادة محليً وعالميا، وبالفعل تضمن الجامعات المصرية ذلك، خاصة إذا حصل الطالب على درجة الدكتوراه من جامعة معتمدة من المجلس الأعلى للجامعات المصرية، الأمر الذي يمنحه قيمة علمية واعترافًا رسميًا واسعًا داخل مصر وخارجها.
شروط القبول في دكتوراه مختبرات طبية في مصر
تختلف شروط القبول في دكتوراه في مصر وفقا للائحة الدراسات العليا بالجامعة المختارة، لكن بشكل عام تضع جميع الجامعات المصرية مجموعة من الشروط الأساسية للقبول من أهمها:
- حصول الطالب المتقدم على درجة الماجستير في المختبرات الطبية أو تخصص قريب منها.
- أن تكون شهادة المؤهل من جامعة معترف بها من قبل المجلس الأعلى للجامعات المصرية.
- حصول الطالب المتقدم على معدل يتراوح ما بين(مقبول وجيد) كحد أدنى، وتحدد القيمة الفعلية وفقا للجامعة المختارة والتخصص.
- أن يعادل الطالب شهادة الماجستير الخاصة به من المجلس الأعلى للجامعات.
- أن يرفع الطالب جميع المستندات المطلوبة بعد توثيقها من وزارة الخارجية والسفارة المصرية بدولته.
- أن يلتزم بسداد رسوم الدراسة والقيد خلال الوقت المحدد.
تكلفة دراسة دكتوراه مختبرات طبية في مصر في الجامعات الحكومية والخاصة
تتفاوت تكلفة دراسة دكتوراه مختبرات طبية في مصر حسب طبيعة الجامعة المختارة سواء كانت جامعة حكومية أو خاصة، حيث تصل تكلفة دراسة الدكتوراه في الجامعات الحكومية إلى: 5000 دولار أمريكي مضاف لها رسوم القيد الجامعي لأول مرة، والتي تقدر بنحو 1500 دولار، وبعض الرسوم الإدارية الأخري.
في حين يصعب تحديد قيمة مطلقة لبرنامج دراسة دكتوراه مختبرات طبية في الجامعات الخاصة، لاختلاف التكلفة وفقًا لسياسة كل جامعة ومصروفاتها الإدارية، لذا يمكنك الاستفسار عن التكلفة عبر استشارة مجانية من مكتب “ادرس في مصر”.
مدة دراسة دكتوراه مختبرات طبية في مصر ونظام الدراسة الأكاديمي
تتبع أغلب الجامعات المصرية وإن لم يكن جميعها نظام الساعات المعتمدة
بكليات “تكنولوجيا العلوم الصحية التطبيقية”، وتحدد مدة ثلاث سنوات كحد أدنى للحصول على درجة الدكتوراه.
أفضل الجامعات التي تقدم برنامج دكتوراه مختبرات طبية في مصر
تبرز جامعة بني سويف كأفضل الجامعات المصرية التي تقدم برنامج دكتوراه مختبرات طبية، حيث تقدم حزمة متكاملة من برامج الدكتوراه في صميم المختبرات الطبية التي تجمع بين بعض تخصصات الكيمياء الحيوية الطبية، الميكروبيولوجيا، والباثولوجيا الإكلينيكية، وتدعمها ببنية تحتية وبحثية متطورة وبيئة أكاديمية تشجع على التخصص بتكاليف تنافسية.
التخصصات المتاحة ضمن برنامج دكتوراه مختبرات طبية في مصر
يرتكز برنامج دكتوراه مختبرات طبية في مصر على مجموعة من التخصصات والمجالات العلمية، من أهمها:
- علم أمراض الدم.
- الكيمياء الحيوية.
- الأحياء الدقيقة.
- المناعة والأمصال.
- الأنسجة والخلايا.
- بنك الدم.
ويتعمق الطالب في تخصص المختبرات الطبية، بدراسة مجموعة من المقررات من أهمها:
- تقنيات المختبر التحليلي في البيولوجيا الجزيئية.
- تقنيات المختبر التحليلي في فرز الخلايا.
- تقنيات التحليل العملي للعينات المصلية.
- تحضير المزارع وتقنيات الكائنات الدقيقة.
- تقنيات الصبغة المخبرية.
- السلامة المخبرية والبيئية.
- علم الطفيليات المتقدم.
- تقنيات المختبرات التحليلية في الطب الشرعي والقانوني.
فرص العمل بعد الحصول على دكتوراه مختبرات طبية في مصر
عندما يتعمق الباحث في مجال المختبرات الطبية بالالتحاق ببرنامج “دكتوراه مختبرات طبية في مصر” ويتخرج يجد نفسه أمام بوابة واسعة من الفرص الوظيفية مثل:
- العمل كاستشاري مختبرات طبية في المستشفيات أو المراكز الطبية، وذلك لمساعدة الأطباء على تحديد السبب الدقيق للمرض من خلال تفسير النتائج المعقدة بالتحاليل الدقيقة.
- يكون الخريج مؤهلا لإدارة مختبر كامل أو مدير جودة بشكل خاص، يتولى مسئولية وضع السياسات والإجراءات وفقا لمعايير الجودة العالمية.
- العمل في إحدى شركات الأدوية والتكنولوجيا الحيوية.
- العمل الأكاديمي كمسار عمل طبيعي يهدف إلى نقل الخبرات للأجيال القادمة بتدريس التخصص داخل الكليات الطبية.
- فضلا عن أنه يصبح مؤهلا لعمل كخبير علمي في هيئات ومنظمات صحية عالمية.
خطوات التقديم في دكتوراه مختبرات طبية في مصر للوافدين
تتسم خطوات التقديم على برنامج دكتوراه مختبرات طبية في مصر للوافدين بالمرونة الكاملة حيث؛ أتاحت الجامعات المصرية للطلاب الوافدين التسجيل من خلال الاعتماد على وكيل تعليمي موثوق، مثل مكتب” ادرس في مصر” لتيسير الإجراءات على الطلاب دون حاجة إلى السفر إلى مصر، وذلك باتباع الإجراءات التالية:
- التواصل مع مكتب ادرس في مصر.
- إرسال المستندات المطلوبة للمكتب ومن أهمها:
يرسل الطالب الوافد إلى مكتب “ادرس في مصر” عبر تطبيق واتساب، نسخ من المستندات التالية:
- شهادة الماجستير في التخصص أو تخصص قريب منه.
- معادلة المؤهل من المجلس الأعلى للجامعات المصرية.
- سجل درجات أكاديمي.
- شهادة الميلاد.
- جواز سفر.
- 4 صور شخصية.
- إرسال أصول المستندات المطلوبة للحصول على القبول النهائي
بعد أن يحصل مكتب ادرس في مصر على القبول المبدئي من الجامعة المختارة يرسل الطالب إليه أصول المستندات السابقة مرفق معها توكيل رسمي بتصديق من وزارة الخارجية والسفارة المصرية بوطنه لإنهاء الإجراءات نيابة عنه.
ومن أهم شركات الشحن الموثوقة لإرسال الملف:
- البريد السريع لدولة الوافد.
- DHL.
- Aramex.
- FedEx.
في ختام حديثنا حول النوايا البحثية لبرنامج “دكتوراه مختبرات طبية في مصر” نتوصل إلى مجموعة من النتائج من أهمها اختيار دراسة التخصص هذا في مصر هو اختيار استراتيجي يوازن بين الحصول على الشهادة المعتمدة والجودة الأكاديمية بتكلفة تنافسية لا مثيل لها، وأن التخرج بشهادة دكتوراه المختبرات الطبية تفتح أمام صاحبها فرص وظيفية مرموقة، والآن وبعد أن أدركت تنوع التخصصات ومرونة شروط الدراسة في الجامعات المصرية، يتبق أمامك خطوة واحدة، وهي النقر على أيقونة واتساب أمامك للتواصل مع مكتب ادرس في مصر وبدء إجراءات التسجيل.


![دراسة ماجستير مختبرات طبية في مصر [current_year]](https://studyinegy.com/wp-content/uploads/2025/10/ماجستير-مختبرات-طبية-في-مصر-300x169.jpg)

![أفضل تخصص فى المختبرات الطبية [current_year]](https://studyinegy.com/wp-content/uploads/2024/11/أفضل-تخصص-فى-المختبرات-الطبية-300x169.webp)
